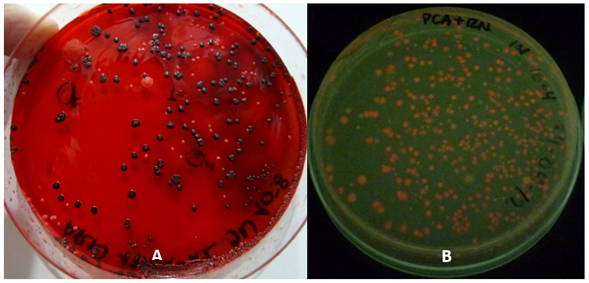

Artículos/Investigación
Aislamiento y caracterización de bacterias productoras de biopolimeros a partir de efluentes industriales
Isolated and characterization of biopolymer producing bacteria from industrial effluents
Aislamiento y caracterización de bacterias productoras de biopolimeros a partir de efluentes industriales
Revista Colombiana de Biotecnología, vol. XXIV, núm. 1, pp. 27-45, 2022
Instituto de Biotecnología, Universidad Nacional de Colombia
Recepción: 15 Agosto 2021
Aprobación: 16 Mayo 2022
RESUMEN: Se realizó una caracterización físico-química de los efluentes procedentes de industrias del sector educación, metalmecánico, lácteos y confitería de la ciudad de Manizales, Caldas; posteriormente se obtuvieron aislamientos, en medios diferenciales suplementados, de bacterias con potencial para la producción de biopolímeros a los cuales se les aplicó pruebas para la caracterización morfológica, bioquímica y molecular. Los parámetros físico químicos obtenidos de los efluentes industriales demuestran diferencias entre ellos, ya que cada industria genera diferentes residuos aportando una determinada contaminación al efluente, se obtuvieron 73 aislamientos productores de exopolisacáridos (EPS) y 101 productores de polihidroxialcanoatos (PHA), con características morfológicas y bioquímicas variables. El estudio muestra que los efluentes industriales son una gran fuente de bacterias de interés para la producción de diversos polímeros microbianos; principalmente aquellos que producen polímeros tipo biopoliésteres intracelulares como PHA, debido a su variabilidad físico-química y nutricional permitiendo que los microorganismos se adapten a diversas características medioambientales y de composición.
Palabras clave: Exopolisacáridos, Polihidroxialcanoatos, Efluente, Industria.
ABSTRACT: A physical-chemical characterization of effluents from industries in the education, metal-mechanic, dairy and confectionery sectors of the city of Manizales, Caldas; Later isolates were obtained, in differential media supplemented, from bacteria with potential for the production of biopolymers to which they were applied tests for morphological, biochemical and molecular characterization. The physical chemical parameters obtained from the industrial effluents show a difference between them, since each industry generates different waste contributing a certain contamination to the effluent, 73 isolates producing exopolysaccharides (EPS) and 101 producers of polyhydroxyalkanoates (PHA) were obtained, with morphological characteristics and variable biochemistry. The study shows that industrial effluents are a great source of bacteria of interest for the production of various microbial polymers; mainly those that produce polymers like intracellular biopolyesters such as PHA, due to their physical-chemical and nutritional variability allowing the microorganisms to adapt to diverse environmental and compositional characteristics.
Keywords: Exopolysaccharides, Polyhydroxyalkanoates, Effluent, Industry.
INTRODUCCIÓN
En la actualidad hay una gran variedad de procesos industriales que son fuentes generadoras de diferentes tipos de residuos de los cuales el 70% se vierten a cuerpos de agua superficiales sin realizarles ningún tipo de tratamiento (Rodríguez et al., 2006), aumentando el deterioro del entorno por su contenido de elementos insolubles, ácidos, bases, metales, elementos orgánicos como azúcares, proteínas, entre otros (Cruz V, 2008), esta alta diversidad de elementos hace de los efluentes industriales una buena fuente para el desarrollo de microorganismos, los cuales por su capacidad de degradar estos compuestos presentan un alto potencial para ser utilizados en procesos de biorremediación y en la producción de sustancias como exopolisacáridos (EPS) y polihidroxialcanoatos (PHA), que son materiales con aplicabilidad en varios sectores industriales entre los que se destacan la industria alimenticia, química, farmacéutica, petroquímica y medicina. En el caso específico de EPS han sido utilizados como aditivos, texturizantes, espesantes, estabilizantes, gelificantes, saborizantes, encapsulantes, además son usados por su capacidad para retener metales pesados, agentes antivirales, antitumorales, sustituyentes de plasma sanguíneo entre otras aplicaciones (Nadzir M. et al., 2021; Moscovici M., 2015), esta variedad de usos hace de los polímeros microbianos sustancias con buen potencial de industrialización y comercialización (Amadu et al., 2021).
Los efluentes industriales presentan diferencias en su composición y proporción de residuos de acuerdo con el tipo de procesos que se realizan en la empresa, pero en general los efluentes contienen una alta carga de materia orgánica (Reyes S, 2009) que puede ser transformada en compuestos no contaminantes por la acción de microorganismos (Sánchez y Rodríguez, 2003), al ser utilizada como sustrato para producir biopolímeros como PHA o EPS (Segura et al., 2007). Los polihidroxialcanoatos son sintetizados en forma de gránulos intracitoplasmáticos de biopolímeros por algunas bacterias al encontrarse sometidas a condiciones ambientales como exceso en la fuente de carbono y carencia de nutrientes como nitrógeno o fosforo entre otros. La producción de PHA de origen microbiano surge como una alternativa para la reducción del uso de algunos tipos de materiales plásticos obtenidos de fuentes no renovables como el petróleo, que por tratarse de polímeros sintéticos no son fácilmente degradables (Anjum et al., 2016; Ali Raza, Abid & Banat, 2018).
Las sustancias poliméricas extracelulares microbianas (EPS) son el grupo de materiales poliméricos renovables y más significativas. La diversidad química y estructural de los EPS les confiere funciones diversificadas en varios campos, como ecología microbiana, medicina, industria láctea, biopelículas, industria agrícola, cosmética, productos farmacéuticos, etc., que representan su importancia biotecnológica (Andhare et al., 2015).
Teniendo en cuenta la gran variedad de compuestos presentes en los efluentes industriales y la capacidad que tienen los microorganismos de utilizarlos como fuente de carbono y energía para producir biopolímeros, se hace necesario el estudio de la población microbiana nativa del efluente de manera que se realice a futuro un aprovechamiento de las características bioquímicas y metabólicas de dichos microorganismos procedentes de efluentes del sector industrial de Manizales, donde aproximadamente cuarenta empresas de la zona industrial Malteria; vierten sus aguas industriales residuales a la quebrada Manizales que, a su vez, entrega sus caudales al río Chinchiná, por lo que sus aguas contaminadas afectan también a otros municipios, como Villamaría y Chinchiná (Botero M., 2015). Para esto es necesario el aislamiento y caracterización de microorganismos propios de dichos efluentes que sean de potencial uso para la biorremediación y otras aplicaciones biotecnológicas, lográndose la conversión de contaminantes en productos de valor agregado como los biopolímeros.
MATERIALES Y MÉTODOS
CARACTERIZACIÓN FISICOQUÍMICA DE LOS EFLUENTES INDUSTRIALES
Se utilizaron efluentes industriales de empresas de la ciudad de Manizales pertenecientes a los sectores de: Educación, Metalmecánico, Confitería y Lácteo, ubicados en la ciudad de Manizales, Caldas. Realizando mediciones de parámetros como pH, temperatura, conductividad, oxígeno disuelto, sólidos disueltos y salinidad directamente en cada uno de los efluentes empleando una sonda multiparámetro de análisis físico químico WTW Multi 3430.
AISLAMIENTO DE BACTERIAS CON POTENCIAL PARA LA PRODUCCIÓN DE BIOPOLÍMEROS
Muestreo: Se realizó el muestreo de los efluentes industriales, de acuerdo con el British Columbia Field Sampling Manual (2013), tomando una muestra compuesta de 100 mL en un frasco de vidrio estéril por duplicado; el cual fue transportado en una nevera de icopor al laboratorio de Biotecnología del Tecnoparque SENA nodo Manizales, para su procesamiento.
Aislamiento de bacterias productoras de EPS: La siembra de las muestras obtenidas de los efluentes industriales se llevó a cabo según la metodología descrita por (Ricciardi et al., 1997; Ruas-Madiedo y De los Reyes-Gavilán, 2005), con algunas modificaciones, realizando diluciones seriadas hasta la dilución 10-10, utilizando diluciones pares y realizando siembra por duplicado.
La siembra se hizo por superficie utilizando 0,1 mL de cada dilución y adicionándola sobre la superficie de placas con agar infusión cerebro corazón (BHI) suplementado con 0,08% (w/v) de rojo congo y 3,6% (w/v) de sacarosa, la muestra se homogenizó con perlas de vidrio estériles, las siembras se incubaron a 37°C durante 72 horas, realizando seguimiento al crecimiento cada 24 horas para evidenciar la presencia de colonias negras u oscuras sobre el medio de cultivo (Freeman et al., 1989).
Después de un crecimiento de 72 horas, se procedió a purificar los aislamientos que evidenciaron presencia de colonias negras, realizando siembra por agotamiento sobre Plate Count Agar (PCA). Estos crecimientos fueron incubados a 37°C durante 24 horas. La conservación de los aislados se realizó en glicerol al 10% a temperaturas de -20 y -80°C (García & Uruburu, 2000; Hernández et al., 2003).
Aislamiento de bacterias productoras de PHA: Las muestras de los efluentes se sembraron por superficie; adicionando 0,1 mL de cada una de las diluciones pares de cada efluente en Agar PCA suplementado con rojo nilo al 0,1% (w/v), incubándose a 37°C. Se realizaron las lecturas bajo luz ultravioleta a una longitud de onda de 362 nm de las colonias que presentaran fluorescencia rosada (Ostle y Holt, 1982; Spiekermann, 1999), a las 24, 48 y 72 horas (Fernández et al., 2006); cada colonia considerada como positiva se purificó en PCA. La conservación de los aislados se realizó en glicerol al 10% a temperaturas de -20 y -80°C (García & Uruburu, 2000; Hernández et al, 2003).
CARACTERIZACIÓN MORFOLÓGICA Y BIOQUÍMICA DE LAS ESPECIES DE BACTERIAS AISLADAS
Caracterización macroscópica de los aislamientos: Las bacterias aisladas se caracterizaron morfológicamente teniendo en cuenta 9 aspectos: forma, margen, elevación, superficie, textura o consistencia, propiedad óptica, tamaño, conformación y color (Villota-Calvachi & Otero-Ramírez, 2009).
Caracterización microscópica de los aislamientos: Los aislamientos fueron caracterizados microscópicamente utilizando la tinción de Gram describiendo la forma presentada por cada uno, para las bacterias productoras de EPS se realizó tinción Negativa para evidenciar la presencia de cápsula (Koneman et al., 2008), y en el caso de las bacterias productoras de PHA se realizó la tinción con Sudan Negro al 0,1% (Pandolfi et al., 2007) para la detección de gránulos intracelulares.
Caracterización bioquímica de los aislamientos: La caracterización bioquímica de los aislamientos seleccionados se realizó de acuerdo a lo descrito por Koneman et al., en 2008; llevándose a cabo 21 pruebas para los microorganismos obtenidos de los efluentes industriales. Dichas pruebas fueron: catalasa, oxidasa, rojo de metilo, Voges-Proskauer, fermentación de 12 azúcares, triple azúcar hierro (TSI), medio sulfuro indol motilidad (SIM), urea, agar hierro lisina (LIA) y citrato de Simmons.
SIMILARIDAD DE BACTERIAS AISLADAS DE EFLUENTES INDUSTRIALES PRODUCTORES DE PHA Y EPS BASADOS EN CARACTERES MICROSCÓPICOS, MACROSCÓPICOS Y BIOQUÍMICOS
Con los resultados de las pruebas microscópicas, macroscópicas y bioquímicas obtenidos, se elaboró una matriz mediante métodos numéricos, de acuerdo a Presencia (1) / Ausencia (0). Está matriz se analizó por medio del paquete estadístico PAST 2.17 el cual realiza una comparación de diversas características, cada una recibe el mismo valor; realizado el análisis de caracteres se calcula para cada par de organismos del grupo un coeficiente de asociación, que es la función que determina la concordancia de estos caracteres que presentan esos organismos, de forma que cada uno se compara con todos los demás de la matriz.
En este estudio utilizamos el coeficiente de Jaccard (SJ), en él, se ignoran todos aquellos caracteres ausentes en los organismos. Ambos coeficientes aumentan linealmente de valor desde 0 (no hay concordancia) a 1 (100% de concordancia). Los organismos con mayor semejanza se agrupan y se encuentran separados de organismos no semejantes, todos estos datos se verán reflejados en dendrogramas para visualizar los agrupamientos de los 104 aislados y la relación entre sí, tomando como referencia porcentajes mayores de 85% para un nivel de similaridad alta.
Adicionalmente se realizó una matriz con bacterias referentes de PHA y EPS para elegir algunas bacterias a las cuales se aplicó una batería de pruebas en sistemas miniaturizados API® 20E, API® 20NE y API® 50CH para una identificación más confiable.
CARACTERIZACIÓN MOLECULAR DE LOS AISLAMIENTOS
Se realizó la recuperación de los aislamientos a partir de los viales criopreservados para lo cual se activó el cultivo mediante un choque térmico a 37°C, con posterior siembra en superficie sobre agar nutritivo (Oxoid, EUA). Se tomó una colonia de cada placa, y se transfirió a 5 ml de caldo nutritivo, el cual se incubó a 37°C y 150 rpm hasta alcanzar un factor de densidad óptica entre 0.9 y 1.0. Para la recuperación de la biomasa, se centrifugó el cultivo en medio líquido durante 10 minutos a 2500 rpm. Se llevó la biomasa resultante a una concentración aproximada de 109 células/mL. La extracción y purificación de ADN genómico se realizó mediante el Kit PureLink® Genomic DNA (Invitrogen, EUA), recomendado para la lisis de bacterias.
La identificación molecular de los aislamientos se realizó mediante la amplificación del Gen 16s rRNA a partir del ADN genómico previamente extraído por PCR. Para ello se utilizaron los cebadores universales RB (5’- AGA GTT TGA TYM TGG CTC AG-3’) y RM (5’- GGA CTA CCA GGG TAT CTA ATC C-3’), con el fin de amplificar un fragmento de aproximadamente 800 pb utilizando el termociclador MS mini (Bio-Rad®, EUA). Una vez amplificado el ADN de la región 16S de cada aislamiento se realizó la secuenciación de los productos de PCR en la compañía Macrogen® (Corea del Sur). A las secuencias obtenidas se les realizó un análisis de calidad usando el programa CLC® Main Workbench (Qiagen Company, EUA). Se desarrolló la anotación de las secuencias usando el programa BLASTN ver. 2.2.27+ contra la base de datos nt del NCBI. Estos resultados fueron filtrados con el 80% de similitud y 80% de cobertura de la región que estaba amplificando con los primers descritos en el numeral anterior. Una vez obtenidas las descripciones por BLAST se procedió a construir la base de datos para los alineamientos de acuerdo con los taxones que cumplieron con las características para ser considerados como un acierto (hit). Para el alineamiento se usó el software Clustal W ver. 2.1 y el resultado se usó como entrada (input) al programa de análisis filogenético Mega 5 ver. 5.2.2, utilizando el método de Neighbor-Joining, con base en las distancias medias, asumiendo una tasa de mutación uniforme; la topología del árbol se evaluó utilizando bootstrap con 10000 submuestreos.
RESULTADOS Y DISCUSIÓN
CARACTERIZACIÓN FISICOQUÍMICA DE LOS EFLUENTES INDUSTRIALES
Los parámetros físico químicos obtenidos de los efluentes industriales son muy variables entre sí, ya que cada industria genera diferentes residuos aportando una determinada contaminación al efluente por lo tanto, las bacterias nativas de estos efluentes pueden desarrollarse en ambientes y bajo condiciones muy diferentes, utilizando dichas características para su crecimiento y reproducción (Tabla 1) (Corton & Viale, 2006). De acuerdo con Tortora et al., (2013), las bacterias, en general, se desarrollan con mayor facilidad a un pH próximo a la neutralidad o ligeramente alcalino, pero la mayoría toleran un pH que se encuentre entre 5 y 9; para el caso específico de bacterias productoras de EPS su rango optimo esta entre 6 y 8 de acuerdo con Torres et al., (2012) y entre 5.5 y 9.5 para productoras de PHA (Saharan, Grewal & Kumar, 2014).

Los efluentes industriales analizados difieren en sus temperaturas, a pesar de esto se puede inferir que el rango de temperatura presentado es adecuado para el desarrollo de microorganismos mesófilos, ya que estos microorganismos tienen un límite mínimo de crecimiento de 10°C, una temperatura óptima de crecimiento de 37°C y un límite máximo de crecimiento de 40°C, por lo cual se encuentran abundantemente en la naturaleza (Tortora et al., 2013).
Generalmente la materia disuelta está constituida por materia orgánica e inorgánica presente en el efluente, la cual constituye la principal fuente de energía y de carbono necesaria para el crecimiento de los microorganismos (principalmente bacterias), otro parámetro de gran importancia es el oxígeno disuelto ya que facilita la realización de procesos bioquímicos con los cuales las bacterias logran la degradación de la materia orgánica presente en el efluente industrial (Rodríguez et al., 2006), en los efluentes hay presencia de oxígeno disuelto lo que indica que los microorganismos pueden ser aerobios o anaerobios facultativos.
La conductividad expresa la capacidad que presenta el agua de transportar una corriente eléctrica y está directamente relacionada con la concentración de iones, por lo cual; es una forma de medir indirectamente la salinidad del agua. En el efluente del sector metalmecánico la conductividad es muy baja y la salinidad es alta, en comparación con los datos obtenidos de los demás efluentes (Tortora et al, 2013).
La concentración de iones (sales) en los efluentes, es un parámetro de gran importancia para el desarrollo bacteriano. Un contenido de sal por encima del 2% inhibe el crecimiento de la mayoría de las bacterias (Tortora et al., 2013). Al analizar los datos tomados se puede notar que en los efluentes industriales de las empresa del sector educativo, confitería y lácteos la concentración de sal es menor al 2%, por lo cual no se ve afectado el desarrollo microbiano; el efluente de la empresa perteneciente al sector metalmecánico presentó mayor salinidad en comparación con los demás efluentes, lo cual indica que los microorganismos nativos de este efluente son halófilos facultativos los cuales pueden crecer en concentraciones de sal hasta del 15%.
AISLAMIENTO DE BACTERIAS CON POTENCIAL PARA LA PRODUCCIÓN DE BIOPOLÍMEROS
Aislamiento de bacterias productoras de EPS: Se evidenció el crecimiento de gran variedad de colonias (negras, blancas, rojas, rosadas), pero únicamente se aislaron y purificaron las colonias negras, de acuerdo con la metodología descrita por Freeman et al., (1989). En total se aislaron 73 morfotipos diferente productores de EPS. (Tabla 2).

El uso del colorante rojo congo en una concentración del 0,08% (w/v) permitió evidenciar colonias de color negro (Figura 1), pero de acuerdo con lo descrito por Pérez-Ordoyo., (2010) un aumento en la concentración del colorante rojo congo puede intensificar el color en las colonias productoras de EPS y las cepas no productoras conservarán su color inicial, por lo tanto el colorante rojo congo se puede utilizar hasta una concentración de 0,12% (w/v).
Figura 1
Crecimiento inicial de colonias aisladas de efluentes industriales sobre agar BHI suplementado con rojo Congo y sacarosa (A) y PCA suplementado con Rojo Nilo (B)
Según Freeman et al., (1989), el uso de suplementos de azúcar como glucosa o sacarosa es esencial para la detección de bacterias productoras de exopolisacáridos utilizando el método del rojo congo, Lancheros, (2001), encontró que el uso de la sacarosa en concentraciones de 10g/L y mayores promueven la producción de EPS, lo que indica que la concentración de 36g/L utilizada fue adecuada y permitió a las bacterias la correcta utilización de la sacarosa en la producción del biopolímero extracelular.
Aislamiento de bacterias productoras de PHA: Se aislaron en total 101 colonias de bacterias procedentes de los efluentes industriales (Tabla 2), que presentaron fluorescencia rosada en un tiempo comprendido entre 24 y 72 horas (Figura 1).
El medio de cultivo utilizado para realizar el aislamiento, suplementado con el colorante lipofílico rojo nilo permitió aislar y diferenciar las bacterias posiblemente productoras de PHA de aquellas que no poseen esta característica, ya que las colonias acumuladoras de este tipo de biopolímero emiten fluorescencia al ser observadas en una lámpara de U.V por la combinación del colorante con material lipídico del gránulo intracitoplasmático de PHA (Bello y Brandl , 2007) el cual se encuentra rodeado por una monocapa fosfolipídica (González G et al., 2013). El aislamiento de estas bacterias mediante la técnica con el colorante rojo nilo fue una prueba cualitativa, realizada de manera fácil y permitió obtener resultados rápidos.
CARACTERIZACIÓN MORFOLÓGICA Y BIOQUÍMICA DE LAS BACTERIAS AISLADAS
Caracterización macroscópica de los aislamientos productores de EPS y PHA: Se realizó la caracterización macroscópica a los 174 aislamientos obtenidos, pero teniendo en cuenta la similitud presentada por los aislamientos se seleccionaron 10 (entre productores de PHA y EPS) de cada empresa para las fases siguientes del estudio.
Al realizar la descripción de la morfología macroscópica presentada por las colonias aisladas de los efluentes industriales se puede notar que las colonias obtenidas de los cuatro efluentes industriales presentan diferencias en cuanto a este aspecto, lo cual es indicativo de la gran diversidad microbiana, presente, con capacidad para la producción de estos biopolímeros. Según Rodríguez et al. (2006), los efluentes industriales son una buena fuente para el desarrollo de microorganismos debido a la capacidad metabólica de los mismos para utilizar y eliminar diversas sustancias y componentes presentes en ellos. Estas características aportan información para la posterior identificación y taxonomía del grupo de bacterias al que pertenecen. Las características de mayor predominancia entre los microorganismos productores de EPS y PHA, fueron en cuanto a Forma: circular, Margen: entero, Elevación: elevada, Superficie: lisa, Textura: cremosa, Propiedad óptica: brillante, Configuración: redonda y Color: beige.
Caracterización microscópica de los aislamientos productores de EPS y PHA: El resultado de la descripción microscópica general realizada a las 40 bacterias fue la presencia de Bacilos Gram negativos, Bacilos Gram positivos, Cocos Gram positivos y Cocos Gram negativos (Tabla 3, Figura 2), lo que refleja que una gran variedad de microorganismos tiene la capacidad de producción de biopolímeros. Observando las bacterias productoras de EPS y de acuerdo con lo descrito por Malaka R., (2021) y Ventorino et al., (2019), tanto bacterias Gram positivas como Gram negativas pueden producir exopolisacáridos.


Figura 2
Características microscópicas de aislados productores de EPS A. Tinción de Gram B. Tinción negativa.
En general, en los efluentes industriales hubo mayor presencia de Bacilos Gram negativos que de acuerdo con Ruas-Madiedo y De los Reyes-Gavilan, (2005), en la industria de alimentos tienen gran utilidad algunos exopolisacáridos producidos por bacterias Gram negativas como Xanthomonas campestris y Acetobacter xylinum las cuales son bacilos que producen xantano y acetano respectivamente, biopolímeros utilizados para modificar las propiedades reológicas en algunos productos.
En los efluentes de las industrias perteneciente a los sectores metalmecánico y confitería los bacilos Gram negativos están en mayor proporción (Figura 3), a pesar de esto se debe notar que en el efluente de la industria del sector lácteo hay presencia de bacilos y cocos tanto Gram negativos como Gram positivos, lo que convierte a este efluente en una buena fuente de microorganismos productores de varios tipos de exopolisacáridos.
Con respecto a las bacterias productoras de PHA; los aislamientos de los efluentes de las empresas pertenecientes a los cuatro sectores son en su mayoría bacilos Gram negativos (Tabla 4), lo cual indica que estos efluentes contienen las condiciones adecuadas para el desarrollo de estos microorganismos con potencial para la producción de PHA (Díaz, 2012). Algunas bacterias Gram negativas productoras de PHA son Pseudomonas aeruginosa (Serrano R., 2010), Azospirillum brasilense (Martínez et al 2004) y Azotobacter vinelandii (Carminatti et al., 2006). La presencia en los efluentes de bacterias tanto Gram positivas como Gram negativas indican la capacidad que poseen ambos grupos microbianos de sintetizar gránulos de PHA (Segura et al., 2007; Carminatti et al., 2006). En los efluentes de las empresas del sector educativo y confitería se observó mayor diversidad morfológica, en comparación con las empresas de los otros dos sectores.

Al realizar tinción negativa se observó la presencia de cápsula en la totalidad de los aislamientos lo cual según Franco R., (2004), pone de manifiesto la producción de exopolisacáridos capsulares unidos a la pared celular.
Caracterización bioquímica de los aislamientos productores de EPS y PHA: Las pruebas bioquímicas se realizaron a los microorganismos procedentes de 2 de los 4 efluentes industriales (metalmecánico y confitería) utilizados en este estudio, por interés propio de la investigación.
El 66,7% de los productores de EPS y el 16,6% de las bacterias productoras de PHA correspondientes al efluente del sector metalmecánico; asi como el 71,43% y el 100% de los aislamientos productores de EPS y PHA respectivamente, del efluente del sector confitería fueron catalasa positiva (Tabla 5) (Marrero C., 2006; Koneman et al., 2008).
Todos los microorganismos productores de EPS, pertenecientes a los dos sectores anteriormente mensionados fueron oxidasa negativa, por lo tanto dichos aislamientos pueden ser anaerobios facultativos, ya que para su desarrollo no necesitan el oxígeno, pero si esta presente lo utilizan para su metabolismo (Montoya V, 2008). Algunos bacilos Gram negativos como los miembros de las familias Enterobacteriaceae, especies de Acinetobacter y Stenotrophomonas maltophilia, no producen la enzima oxidasa (Forbes, 2009). Contrario a los aislamientos productores de PHA donde el 100% provenientes del sector metalmecánico y un 11,1% del sector confiteria presentan la enzima citocromo que actúa en la respiración aerobica; dando resultados positivos a esta prueba (Tabla 5) (Marrero C., 2006; Koneman et al., 2008).

En los efluentes industriales hay presencia de materia orgánica la cual es degradada por los microorganismos utilizando para ello el oxígeno disuelto presente en el agua, este proceso de biodegradación de materia orgánica favorece el crecimiento microbiano lo cual genera agotamiento del oxígeno y lo limita en el efluente, estos bajos niveles de oxigeno disuelto inhiben el desarrollo de microorganismos oxidasa positivos y se promueve el crecimiento de anaerobios facultativos (Rodríguez et al., 2006).
Las Enterobacterias tienen la capacidad de fermentar la glucosa mediante la vía ácido mixta o la vía 2,3 butanodiólica, produciendo variedad de compuestos tras los procesos de fermentación, estos compuestos pueden ser ácidos orgánicos, alcoholes y gases como dióxido de carbono e hidrógeno lo cual depende del tipo de microorganismo, del sustrato utilizado por cada uno de ellos y de las enzimas que estén presentes (Rodríguez et al., 2006).
El resultado positivo en la prueba de Rojo de Metilo indica que el 55,5% de aislados procedentes del sector metalmecánico y el 85,7% procedentes del sector confitería, son productores de EPS; así como el 88,8% de aislados productores de PHA provenientes del mismo sector (confitería), tienen la capacidad de utilizar la vía ácido mixta para fermentar la glucosa y generar como productos finales de la fermentación grandes cantidades de ácidos orgánicos fuertes como (láctico, fórmico, acético) (Tabla 6), (Marrero, 2006; Koneman et al., 2008). Esta alta producción de ácidos contribuye a bajar el pH lo cual fue evidenciado con el valor obtenido en el efluente de esta empresa el cual registro un pH 6.2. El 100% de las bacterias aisladas del efluente metalmecánico fueron negativas para la prueba de rojo de metilo indicando que pueden generar ácidos débiles, pero debido a su baja concentración de hidrogeniones (H+) su tendencia va a ser a la neutralidad (Bailón et al., 2004).

Solo el 14,3% de los microorganismos del sector confitería, productores de EPS, fue positivo en la prueba Voges-Proskauer, lo cual pone de manifiesto la capacidad de este aislamiento de fermentar la glucosa usando la vía 2,3 butanodiólica mediante la cual se produce la acetoína que es un precursor en la producción del 2,3 butanodiol (Allaer, 2003). El 100% de los aislamientos del efluente metalmecánico y el 77.7% de los aislamientos del sector confitería, productores de PHA, fueron negativos para esta prueba. La alta proporción de aislamientos negativos para esta prueba indica que los microorganismos no tienen la capacidad de producir alcoholes al fermentar la glucosa, pues no se genera acetoína la cual se acumula cuando los microorganismos crecen en aerobiosis y en los efluentes industriales los niveles de oxígeno disuelto promueven el desarrollo de anaerobios facultativos (MacFaddin, 2003; Koneman et al., 2008).
En referencia a la utilización de carbohidratos como fuente de carbono y energía, el 100% de los microorganismos aislados del efluente industrial del sector metalmecánico tienen la capacidad de degradar el monosacárido glucosa, el 77,7% son fermentadores de sacarosa y el 11,1% fermentan los demás carbohidratos evaluados excepto la lactosa que no es metabolizada por ninguno de los aislamientos provenientes de este efluente, esto en lo que tiene que ver con los aislados productores de EPS. Para este mismo sector el 83.33% de los aislamientos de origen metalmecánico, productores de PHA, no fermentaron ningún tipo de azúcar, esto demuestra que probablemente la única fuente de carbono y energía para dichas bacterias proviene de la capacidad de utilizar el citrato. El 16.66% fermentó solamente la sacarosa, lo que evidencia que este efluente puede presentar un bajo contenido de carbohidratos, dado que la mayoría de bacterias aisladas no asimilaron ningún tipo de azúcar.
Los microorganismos procedentes del efluente del sector confitería que producen EPS, varían mucho en cuanto a la utilización de los diversos azúcares, pero de manera general todos los aislamientos tienen capacidad de utilizar sacarosa y glucosa, el 71,4% pueden utilizar a parte de glucosa y sacarosa, fructosa, manosa, manitol o ribosa y el 57, 1% pueden metabolizar el resto de azucares evaluados. Las bacterias productoras de PHA aisladas del mismo efluente asimilaron y fermentaron en un 66.7% glucosa, maltosa y galactosa; 55.5% arabinosa y manosa; 44.4% sacarosa, fructosa y manitol; 33.3% lactosa y ribosa; 22.2% xilosa y ramnosa. Este hecho evidencia que estos aislamientos tienen una amplia capacidad de degradar y metabolizar diversos mono y disacáridos, debido a que son nativos de un efluente rico en azúcares y compuestos orgánicos, los cuales son degradados para ser utilizados como fuentes de carbono y energía (Koneman et al., 2008)
Según Marrero, (2006), la movilidad es de gran importancia en la identificación de microorganismos y al analizar esta característica se observa que los aislamientos productores de EPS, procedentes del sector metalmecánico son móviles en un 66,7% así como el 71,4% de los aislamientos del sector confitería (Tabla 7). Para los aislados productores de PHA; el 44,4% de las bacterias aisladas del sector confitería y el 16,6% de las bacterias del sector metalmecánico presentaron movilidad, esto muestra que dichas bacterias pueden presentar flagelos o cilios que permiten su locomoción (MacFaddin, 2003).

Los aislamientos GIBI_000271_IN_B del efluente metalmecánico y GIBI_000292_IN_B del efluente de confitería, productores de EPS, fueron positivos para la producción de H2S el cual produce un precipitado negro de sulfuro de hierro. La producción de H2S se lleva a cabo en un ambiente ácido y en los efluentes analizados los valores de pH tienden a la neutralidad o son alcalinos lo que inhibe la capacidad bacteriana de producirlo (Marrero, 2006; Koneman et al., 2008). La producción de H2S fue negativa en un 100% y 66.66% para las bacterias aisladas de los efluentes metalmecánico y confitería respectivamente productoras de PHA, lo que indica que estos microorganismos no presentan la enzima requerida para liberar azufre de los aminoácidos que lo contienen para producir H2S; esta reacción debe llevarse a cabo en un medio ácido (MacFaddin. 2003) lo cual para el primer efluente podría ser posible ya que registro un valor de pH básico de 9.1.
De acuerdo con Koneman et al., (2008) y Forbes (2009), para la producción de indol es necesario que las bacterias cuenten con la enzima triptofanasa para hidrolizar y desaminar el triptófano produciendo indol, ácido pirúvico y amoniaco lo cual evidencia la capacidad de los microorganismos de degradar y metabolizar proteínas y sólo el aislamiento GIBI_000271_IN_B, productor de EPS, perteneciente al efluente metalmecánico presentó resultado positivo para esta prueba.
Según lo descrito por Marrero, (2006), la hidrólisis de la urea es llevada a cabo por los microorganismos que poseen la enzima ureasa los cuales poseen la capacidad de degradar la urea produciendo amonio el cual es utilizado como fuente de Nitrógeno inorgánico, el amonio cambia el pH del medio alcalinizándolo, esto concuerda con el pH de 9,129 presentado por el efluente metalmecánico, donde el 22,22% (2 aislamientos) de los microorganismos aislados poseen esta enzima; del efluente del sector confitería el 57,14% (4 aislamientos) la poseen, lo cual es un indicador de la capacidad que tienen estos aislamientos de utilizar el nitrógeno inorgánico obtenido de la urea para biosíntesis de aminoácidos y proteínas.
La enzima ureasa está presente en diversos microorganismos principalmente gram negativos como especies de Proteus, los cuales son degradadores rápidos de la urea (reacción positiva en 1 o 2 horas) y especies de Klebsiella que son degradadores lentos de la urea (reacción positiva en 3 días o más) y en microorganismos como Enterobacter, y Helicobacter pylori y en microorganismos gram positivos como Corynebacterium urealyticum (Marrero, 2006; Koneman et al., 2008; Forbes, 2009). El 66,66% de los aislamientos del sector confitería y productores de PHA; presentan la enzima ureasa la cual posee la capacidad de hidrolizar la urea lo que produce que sean liberadas moléculas de amonio pudiendo ser utilizadas por las bacterias como fuente de nitrógeno. En lo referente a los aislamientos productores de EPS son positivos a esta reacción en un 22,2 y 57,1% correspondientes a los sectores metalmecánico y confitería respectivamente.
El 88,88% de los aislamientos productores de EPS, procedentes del efluente metalmecánico cuentan con la enzima Lisina descarboxilasa y proceden de un efluente con pH alcalino a causa de la amina cadaverina generada por el proceso de descarboxilación de la lisina la cual alcaliniza el medio. En los aislamientos del efluente de confitería el 71,4% cuentan con la presencia de la enzima. El proceso de la descarboxilación de la lisina indica capacidad enzimática para degradar proteínas en las cuales esté presente el aminoácido lisina que es utilizado como sustrato y como fuente de carbono fermentable la glucosa. El proceso de descarboxilación de la lisina se da en medio ácido por lo cual es necesario que se fermente previamente la glucosa (Koneman et al, 2008). El 83,3% y 77,7% de las bacterias productoras de PHA, aisladas de los efluentes metalmecánico y confitería respectivamente presentan dicha enzima.
El aislamiento GIBI_000272_IN_B, procedente de la empresa metalmecánica y el 28,6% de los procedentes del sector confitería, productores de EPS , son los únicos que cuentan con la enzima desaminasa, con lo cual se evidencia la capacidad de estos aislados de degradar enzimáticamente las proteínas y de utilizar el nitrógeno orgánico proveniente de aminoácidos como lisina y de acuerdo con Koneman et al., (2008) bacterias Gram negativas del género Providencia, Proteus y algunas cepas de Morganella tienen la capacidad de desaminar dicho aminoácido. Un 16,66% (metalmecánico) y 11,11% (confitería), productores de PHA, tienen la capacidad de desaminar la lisina produciendo el ión amonio (NH4+) como producto secundario (Rodríguez et al., 2005), pudiendo ser utilizado por las bacterias como una fuente de nitrógeno.
Solo 2 aislamientos del efluente metalmecánico (22,22%) y 5 aislamientos del efluente confitería (71,42%), productores de EPS, poseen la capacidad de metabolizar el citrato de sodio y utilizarlo como fuente de energía para llevar a cabo procesos de biosíntesis (Koneman et al. 2008 ; Rodríguez et al., 2006). Con respecto a los productores de PHA, las bacterias aisladas del efluente metalmecánico fueron positivas en un 83,33% y las del sector confitería en un 66,66%.
SIMILARIDAD BASADA EN CARACTERES MICROSCÓPICOS, MACROSCÓPICOS Y BIOQUÍMICOS DE LOS AISLAMIENTOS PRODUCTORES DE PHA Y EPS
Mediante el análisis usando el coeficiente de Jaccard (SJ) se encontraron 10 morfotipos diferentes para bacterias productoras de EPS Gram positivas, 15 para Gram negativas, 10 morfotipos para productoras de PHA Gram positivas y 5 para Gram negativas, tomando un porcentaje de similitud de 85%.
En la figura 3 se aprecian 3 grupos representativos que comparten aproximadamente un 54% de similitud, con varios microorganismos cada uno. El primero constituido por microorganismos procedentes de los sectores lácteo y metalmecánico (Gibi311- Gibi000277), el segundo por los sectores lácteo, confitería y educación (Gibi309- Gibi312- Gibi000296- Gibi255- Gibi000297) donde se observa que Gibi309 y Gibi312 tienen un porcentaje de similitud del 88% por lo que se consideran del mismo género; el tercer grupo con un 66% con aislados de los sectores educación, lácteo y metalmecánico (Gibi258- Gibi315- Gibi000273- Gibi310).

Figura 3
Dendrograma de bacterias Gram positivas productoras de EPS.
La figura 4 se destacan 5 grupos compartiendo un 39% de similaridad con varios microorganismos cada uno, constituidos por las 5 empresas estudiadas, el primero muy emparentado con un 80% de similitud se puede considerar del mismo género, estimando EPS 11 y EPS 12 iguales con un 97% de similitud, los demás grupos representando un gran porcentaje de semejanza ya que se pueden valorar similitudes mayores al 85% y considerarse del mismo género estos morfotipos con relación a los caracteres microscópicos, macroscópicos y bioquímicos.

Figura 4
Dendrograma de bacterias Gram negativas productoras de EPS
En la figura 5 se observan 2 grupos representativos con un 49% de similitud conformados por los sectores confitería y educación, el segundo tiene cepas más emparentadas con un 72% con aislados pertenecientes al sector lácteo demostrando que PHA3-PHA4 y PHA9-PHA10 son los morfotipos con un alto porcentaje de similitud previendo ser la misma especie.

Figura 5
Dendrograma de bacterias Gram positivas productoras de PHA.
El índice de similitud que se evidencia en la Figura 6 es un 46%, presentando 2 grupos con varios microorganismos de cada uno de las empresas, el primero se observa con un porcentaje de similitud del 58% aproximadamente, con 2 morfotipos destacándose Gibi280 y Gibi284 con un 94% de similitud considerándose iguales, el segundo grupo con un porcentaje de 59% donde se destacan Gibi329 y Gibi324 con una similitud de 83% considerándose del mismo género.

Figura 6
Dendrograma bacterias Gram negativas productoras de PHA.
Referentes bacterianos
Para el análisis de similitud también se adjuntaron referentes bacterianos a las matrices de resultados junto con los aislados de las empresas para relacionarlos y así seleccionar los microorganismos con mayor porcentaje de semejanza con los referentes y aplicarles las pruebas miniaturizadas API. Con los resultados de estas nuevas matrices se seleccionaron los siguientes aislados para realizar la batería de pruebas API 20E: EPS9, GIBI000295, GIBI320,GIBI000271, GIBI324, EPS4, GIBI000284, GIBI322, GIBI000298, EPS2, EPS11, GIBI000289, GIBI313, GIBI000272, GIBI000292, PHA7, GIBI000285, EPS1 se aplicó la batería de API 20NE para GIBI309,GIBI000296, GIBI315, GIBI000273, GIBI322, GIBI000284, GIBI000281, GIBI000285, GIBI314 y las API 50CH para GIBI000277, GIBI000273, GIBI315, GIBI000303, PHA8, PHA3, PHA10,GIBI000296. Los resultados obtenidos con las pruebas API se muestran en la Tabla 8.

IDENTIFICACIÓN MOLECULAR DE LOS AISLAMIENTOS: Por costos se realizó la identificación molecular de trece de los 40 aislamientos, los cuales se seleccionaron de acuerdo a los morfotipos obtenidos y al origen del efluente de donde fue aislado. De estos se pudo identificar hasta género los trece microorganismos y hasta especie 11 de los mismos, teniendo en cuenta el parámetro de identificación de especie en procariotas con este gen, donde el valor umbral se ubica en una identidad del 98.65% (Kim, M., et al. 2014). Se obtuvo la identificación de 7 aislamientos pertenecientes a Enterobacteriales, 5 a Lactobacillales y uno al orden Burkholderiales (Tabla 9).

Los resultados obtenidos se corroboran con diferentes investigaciones, es así como Arshad et al, en 2013, evaluaron 18 aislamientos obtenidos de ambientes contaminados y no contaminados para la producción de biopolímeros (PHA y EPS). Del total de cepas aisladas 9 presentaron la formación de gránulos dentro de las células, lo cual es indicativo de la producción de PHA; de estas cepas 4 dieron positivo para la producción de exopolisacáridos. Basados en pruebas bioquímicas determinaron que las cepas correspondían a los géneros Pseudomonas, Citrobacter, Enterobacter, Klebsiella, Escherichia y Bacillus. Así mismo Echavarría, Martínez y Montoya en 2013 utilizando subproductos lácteos y de caña de azúcar lograron identificar 38 cepas productoras de PHA, mediante identificación del gen phaC, representando 18 morfotipos bacterianos pertenecientes a los géneros Lactococcus, Klebsiella, Pseudomonas, Enterobacter, Enterococcus, Bacillus, Pantoea y Gluconobacter; coincidiendo con algunos de los géneros encontrados en este estudio.
Las bacterias ácido lácticas han demostrado gran potencial como productoras de sustancias poliméricas extracelulares, como lo demuestra Xu et al., en 2017; quienes fermentaron harina de haba con Leuconostoc spp, uno de los géneros identificados en el estudio, y Weissella spp. con y sin la adición de sacarosa para evaluar su potencial en la producción de EPS; encontrando que la cepa de Leuconostoc spp. DSM 20193 muestra un alto potencial en la producción del polímero y en la modificación de las propiedades reológicas de la pasta de habas.
Bruwal et al., en 2013 utilizando lodos y aguas residuales provenientes de las industrias de papel, celulosa y cartón; identificaron los aislados de Enterococcus sp. NAP11 y Brevundimonas sp. NAC1 como buenos candidatos para la producción industrial de polihidroxibutirato (PHB). En 2009 Mostafa, El-Mezawy y Heller identificaron una cepa de Enterococcus faecium como productora de exopolisacáridos aislada a partir de heces de infantes Egipcios; la cepa logor una producción máxima de 23g/L luego de 6 horas de fermentación en medio M17 suplementado con 1% de sacarosa.
El género Burkholderia comprende más de 60 especies capaces de adaptarse a un amplio rango de ambientes tales como suelo y agua; dentro de las propiedades de esta bacteria está la de producir varios tipos de sustancias poliméricas extracelulares; entre los que se encuentran el cepaciano, levano, PS-I, EPS A, EPS B entre otros (Ferreira et al., 2011). En 2007, Herasimenka et al.; determinaron la producción de EPS por 7 cepas del complejo Burkholderia cepacea (tres cepas de B. multivorans, tres de B. cenocepacia y una de un miembro Bcc de genovar no determinado); encontrando una gran producción de este biopolímero en especial de cepaciano.
A partir de muestras de rizosfera de caña de azúcar, Shraddha et al., en 2011; lograron el aislamiento de 10 bacterias; de las cuales 6 cepas fueron productoras de PHA, al identificarlas mediante la base de datos, basada en taxonomía numérica, PIBWin (Probabilistic identification of bacteria) determinaron que las bacterias corresponden a: Micrococcus luteus, Micrococcus mucilaginosus, Micrococcus nishinomiyaensis, Micrococcus radiodurans, Streptococcus equinus, Streptococcus raffinolactis, de los cuales M. mucilaginosus y S. raffinolactis son los mayores productores del polímero.
CONCLUSIONES
Se pudieron identificar cepas de Enterobacter spp., Leuconostoc spp. y Pseudomonas spp.; entre otras, las cuales son géneros reportados en los referentes bibliográficos utilizados. La morfología predominante en los efluentes industriales fueron bacilos Gram negativos importantes en la producción de exopolisacáridos de interés comercial como xantano y acetano. Así como también bacilos Gram positivos con buena capacidad de producción de polihidroxialcanoatos. Las pruebas bioquímicas realizadas permiten ver la variedad enzimática presentada por los microorganismos aislados y su capacidad de degradar y metabolizar compuestos orgánicos e inorgánicos presentes en los efluentes industriales lo que representa un gran potencial en la remoción de estos compuestos y en la producción de biopolímeros.
Para finalizar los efluentes industriales utilizados para este estudio, son una fuente prometedora para el aislamiento de bacterias de interés para la producción de diferentes tipos de biopolímeros como son las sustancias poliméricas extracelulares y los polihidroxialcanoatos. Debido a sus diferencias en cuanto a características físico-químicas y composicionales, los efluentes, exponen a los microorganismos nativos a condiciones transitorias, sometiéndolos a periodos alternos de concentraciones fluctuantes de sustrato y a ambientes aerobios y anaerobios, situaciones desequilibradas ante las cuales las bacterias responden produciendo diferentes tipos de biopolímeros ya sea como mecanismos de protección o de superviviencia a ese tipo de condiciones. Dichas características de producción de este tipo de sustancias pueden ser utilizadas dentro de las mismas industrias para plantear sistemas de tratamiento biológicos que permitan no solamente disminuir la carga contaminante de sus efluentes sino también optar por una valorización de sus residuos. Pueden ser utilizados en la mejora o innovación de productos, aprovechando características como el aumento de la reologia importante en productos lácteos. El potencial de estos aislamientos en diferentes tipos de industrias es muy grande y este trabajo demuestra la importancia de mirar hacia esos desechos o efluentes que generan estas empresas para aplicarlos en procesos de mejora propios de cada lugar.
REFERENCIAS BIBLIOGRÁFICAS
Ali Raza Z., Abida S. & Banat I. (2018) Polyhydroxyalkanoates: Characteristics, production, recent developments and applications, International Biodeterioration & Biodegradation, 126:45-56.
Allaert C. & Escolá M. (2003). Métodos de análisis microbiológico de alimentos. España: Díaz de Santos S.A. 272 p.
Amadu A., Qiua S., Gea S., Addico G., Ameka G., Yu Z., Xia W., Abbew A., Shao D., Champagne P. & Wang S. (2021). A review of biopolymer (Poly-β-hydroxybutyrate) synthesis in microbes cultivated on wastewater. Science of The Total Environment. Volume756. https://doi.org/10.1016/j.scitotenv.2020.143729.
Andhare P., Chauhan K., Dave M. & Pathak H. (2015). Microbial Exopolysaccharides: Advances in Applications and Future Prospects, Biotechnology Vol. 3: Microbial Biotechnology.
Anjum A., Zuber M., Zia K., Noreen A., Anjum M. & Tabasum S. (2016). Microbial production of polyhydroxyalkanoates (PHAs) and its copolymers: A review of recent advancements, International Journal of Biological Macromolecules, 89:161-174.
Arshad M., Jamil N., Naheed N. & Hasnain S. (2013). Analysis of bacterial strains from contaminated and non-contaminated sites for the production of biopolymers, African Journal of Microbiology, 1 (1), 009-014.
Bailón L., Cervantes S., González R. (2004). Atlas de pruebas bioquímicas para identificar bacterias, in Facultad de estudios superiores de Zaragoza. Universidad Nacional Autónoma de México.
Bello G D., Brandl H. (2007). Selección de bacterias productoras de Poli-hidroxibutirato. ICIDCA. Sobre los derivados de la caña de azúcar, 41(2): 10-18.
Bhuwal A., Singh G., Aggarwal N., Goyal V. & Yadav A. (2013). Isolation and Screening of Polyhydroxyalkanoates Producing Bacteria from Pulp, Paper, and Cardboard Industry Wastes, International Journal of Biomaterials, Article ID 752821, 10 pages.
Botero M. (2015). La quebrada Manizales, quebrada ambientalmente por la legalidad e ilegalidad de los vertimientos. Summa Iuris, 3(1), 207-233.
British Columbia Field Sampling Manual (2013). Ministry of Water, Land and Air Protection. Laboratory and Systems Management.
Carminatti C., El Messane F., Zanchet B M.C., Rodrigues P.V. (2006). Produção de Polihidroxialcanoatos (PHAs), in Departamento de engenharia química e engenharia de alimentos, Universidade Federal de Santa Catarina: Florianópolis. 10-11.
Corton E., Viale A. (2006). Solucionando grandes problemas ambientales con la ayuda de pequeños amigos: las técnicas de biorremediación. En: Revista científica y técnica de ecología del medio ambiente. Ecosistemas, 15 (3):148-157.
Cruz V D.G. (2008). Remoción de metales por microorganismos productores de polisacáridos. Tesis de Maestría en Tecnología Avanzada. Santiago, Querétano: Centro de investigación de ciencia aplicada y tecnología avanzada. Instituto politécnico Nacional. 88 p.
Díaz F. (2012). Conformado de materiales plásticos. Lecturas de ingeniería, Universidad Nacional Autónoma de México: Cuautitlán Izcalli.15.
Echavarría A., Martínez A. & y Montoya M. (2013). Identificación Molecular de Bacterias Productoras de Polihidroxialcanoatos en Subproductos de Lácteos y Caña de Azúcar. Rev. Fac. Nal. Agr. Medellín, 66(2): 7129-7140.
Fernández I., Ortiz F., Burbano O., Guerrero M., España J. (2006). Influencia de las fuentes de carbono y nitrógeno en el crecimiento bacteriano y síntesis de polihidroxialcanoatos de una cepa de BacillusmicoidesFBL2. Centro de estudios en salud, 1: 34-42.
Ferreira A., Silva I., Oliveira V., Cunha R. & Moreira L. (2011). Insights into the role of extracellular polysaccharides in Burkholderia adaptation to different environments, Frontiers in Cellular and Infection Microbiology, December, Volume 1, Article 16.
Forbes B., Sahm D.F., Weissfeld A.S. (2009). Diagnóstico microbiológico, Editorial MédicaPanamericana.Doce ed. Buenos Aires, Argentina. 1160.
Franco R J.F. (2004). Producción de biopolímeros vía fermentativa utilizando cepas de Rhizobium leguminosarum. Tesis para optar el título de Ingeniero Químico. Manizales, Colombia: Universidad Nacional de Colombia. Departamento de Ingeniería Química. 58 p.
Freeman D., Falkiner F., Keane C. (1989). New method for detecting slime production by coagulase negative staphylococci. Department of Clinical Microbiology, Sir Patrick Dun's Laboratory, St James's Hospital, Dublin, Eire. J Clin Pathol.,42: 872-874.
García MD & Uruburu F. (2000). La conservación de cepas microbianas. 30: 12-16.
González G Y., Meza C J.C., González R O., Córdova L J.A. (2013). Síntesis y biodegradación de polihidroxialcanoatos: plásticos de origen microbiano. Rev. Int. Contam. Ambie, 29(1): 77-115.
González R G. (2009). El eco diseño en el marco de un modelo de gestión ambiental para el manejo de efluentes industriales y domésticos en el lago de Maracaibo, estado Zulia - Venezuela Tesis para optar el título de doctor en Ciencias Ambientales. Maracaibo, Venezuela: Universidad Tecina Americana. 112 p.
Herasimenka Y., Cescutti P., Impallomeni G., Campana S., Taccetti G., Ravenni N., Zanetti F. & Rizzo R. (2007). Exopolysaccharides produced by clinical strains belonging to the Burkholderia cepacia complex, Journal of Cystic Fibrosis, 6: 145-152
Hernández A., Alfaro I., Arrieta R. (2003). Microbiología Industrial. San José de Costa Rica: Universidad estatal a distancia. 251 p.
Koneman E., Allen S., Janda W., Schreckenberger P., Winn W. (2008). Diagnóstico Microbiológico: Texto y Atlas en Color. 6 ed. Buenos Aires, Argentina: Medica Panamericana. 1696 p.
Lancheros, Ruth J. (2001). Producción de Polisacáridos por Fermentación Empleando Cepas de Rhizobium. Universidad Nacional de Colombia.
MacFaddin. (2003). Pruebas bioquímicas para la identificación de bacterias de importancia clínica. 3 ed. Buenos Aires, Argentina.: Médica Panamericana. 839 p.
Malaka R. (2021). Bacterial exopolysaccharides production and their roles for human life. IOP Conf. Ser.: Earth Environ. Sci., 788. doi:10.1088/1755-1315/788/1/012109.
Marrero C D. (2006). Guía para la Identificación de las Bacterias más frecuentes en el Laboratorio de Microbiología Clínica. Hospital pediátrico universitario “Octavio de la concepción y de la Pedraja” laboratorio de microbiología. Holguín. 23 p.
Martínez J.; Rodríguez M.; Fernández A.I. (2004). Producción de polihidroxialcanboatos en bacterias diazótrofas. Influencia de la aeración de poli-B-hidroxibutirato en Azospirillum brasilense cepa 7. Revista Biológica, 18(1): 87-94.
Montoya V H.H. (2008). Microbiología básica para el área de la salud y afines. Editorial Universidad de Antioquía. Segunda ed. Medellín, Colombia. 255.
Moscovici M. (2015). Present and future medical applications of microbial exopolysaccharides. Front. Microbiol., 6:1012. doi:10.3389/fmicb.2015.01012
Mostafa H., El-Mezawy A., Geis A. & Heller K. (2009). Exopolysaccharide production by Enterococcus faecium, Milchwissenschaft 64 (4).
Nadzir M., Nurhayati R., Idris F. & Nguyen M. (2021). Biomedical Applications of Bacterial Exopolysaccharides: A Review. Polymers, 13, 530. https://doi.org/10.3390/polym13040530.
Ostle A., Holt J. (1982). Nile blue A as a fluorescent satín for poly-ᵝ-hidroxybutyrate. Applied and Environmental Microbiology, 44(1): 238-241.
Pandolfi D., Pons M-N & da Motta M. (2007). Characterization of PHB storage in activated sludge extended filamentous bacteria by automated colour image analysis, Biotechnol Lett, 29:1263-1269
Pérez-Ordoyo G L I. (2010). Exopolisacáridos y otros factores de virulencia en cepas de Staphylococcus aisladas de leche ovina. Tesis para optar el grado de Doctor. León.: Universidad de León. Facultad de Veterinaria. Departamento de Salud animal. 320 p.
Reyes S A.M. (2009). Análisis y control del abultamiento filamentoso en una planta de tratamiento de efluentes. Tesis de grado, in Facultad de ciencias químicas Universidad Veracruzana: Coatzacoalcos, Veracruz.
Ricciardi A., P E., CF A. (1997). Simple methods for screening of lactic acid bacteria, for the production of exopolisaccharides in liquid medio. In: Biotecnology Techniques, 11: 271-275.
Rodríguez C E., Gamboa C M.M., Hernández C F., García H J.D. (2005). Bacteriología General: Principios y prácticas de laboratorio. Costa Rica.: Editorial Universidad de Costa Rica. 475 p.
Rodríguez F.A., Leton G.P., Rosal G.R., Dorado V.M., Villar F.S., Sanz G.J. (2006). Tratamiento Avanzado de Aguas Residuales Industriales. Informe de Vigilancia Tecnológica. 136 p.
Ruas-Madiedo P., De los Reyes-Gavilan C.G. (2005). Methods for screening, isolation and characterization of exopolisaccharides produced by lactic acid bacteria. Instituto de productos lácteos de Asturias. American Dairy Science Association. J Dairy Sci, (88): 843-856.
Saharan B., Grewal A. & Kumar P. (2014). Biotechnological Production of Polyhydroxyalkanoates: A Review on Trends and Latest Developments, Chinese Journal of Biology, Article ID 802984
Sánchez M J., Rodríguez G J.L. (2003). Biorremediación. Fundamentos y aspectos microbiológicos. Universidad de Oviedo.
Segura D., Noguez R., Espin G. (2007). Contaminación ambiental y bacterias productoras de plástico biodegradable. En: Biotecnología, 14: 361-371.
Serrano R J.Y. (2010). Polihidroxialcanoatos (PHAs): Biopolímeros producidos por microorganismos. Revista Teoría y Praxis investigativa, 5(2): 79-84
Shraddha G., Yogita R., Simanta S., Aparna S., & Kamlesh S. (2011). Screening and production of bioplastic (PHAs) from sugarcane rhizospheric bacteria, International Multidisciplinary Research Journal, 1(9): 30-33
Spiekermann P., Rehm B., Kalscheuer R., Baumeister D., & Steinbuchel A. (1999). A Sensitive, viable-colony staining method using nile red for direct screening of bacteria that accumulate polihydroxyalkanoic acids and other lipid storage compounds. 73-80.
Torres C., Antunes S., Ricardo A., Grandfils C., Alves V., Freitas F. & Reis M. (2012). Study of the interactive effect of temperature and pH on exopolysaccharide production by Enterobacter A47 using multivariate statistical analysis, Bioresource Technology, 119:148-156
Tortora G J., Funke B R., Case C L. (2013). Microbiology an introduction, Eleventh Edition, Pearson education Inc.
Ventorino V., Nicolaus B., Di Donato P., Pagliano G., Poli A., Robertiello A., Iavarone V. & Pepe O. (2019). Bioprospecting of exopolysaccharide-producing bacteria from diferent natural ecosystems for biopolymer synthesis from vinasse. Chem. Biol. Technol. Agric., 6:18. https://doi.org/10.1186/s40538-019-0154-3.
Villota-Calvachi G. & Otero-Ramírez I. (2009). Características culturales de bacterias cultivables, Grupo de Biotecnología Microbiana, Universidad de Nariño.
Xu Y., Wang Y., Coda R., Säde E., Tuomainen P., Tenkanen M. & Katina K. (2017). In situ synthesis of exopolysaccharides by Leuconostoc spp. and Weissella spp. and their rheological impacts in fava bean flour, International Journal of Food Microbiology, Volume248, Pages 63-71.
